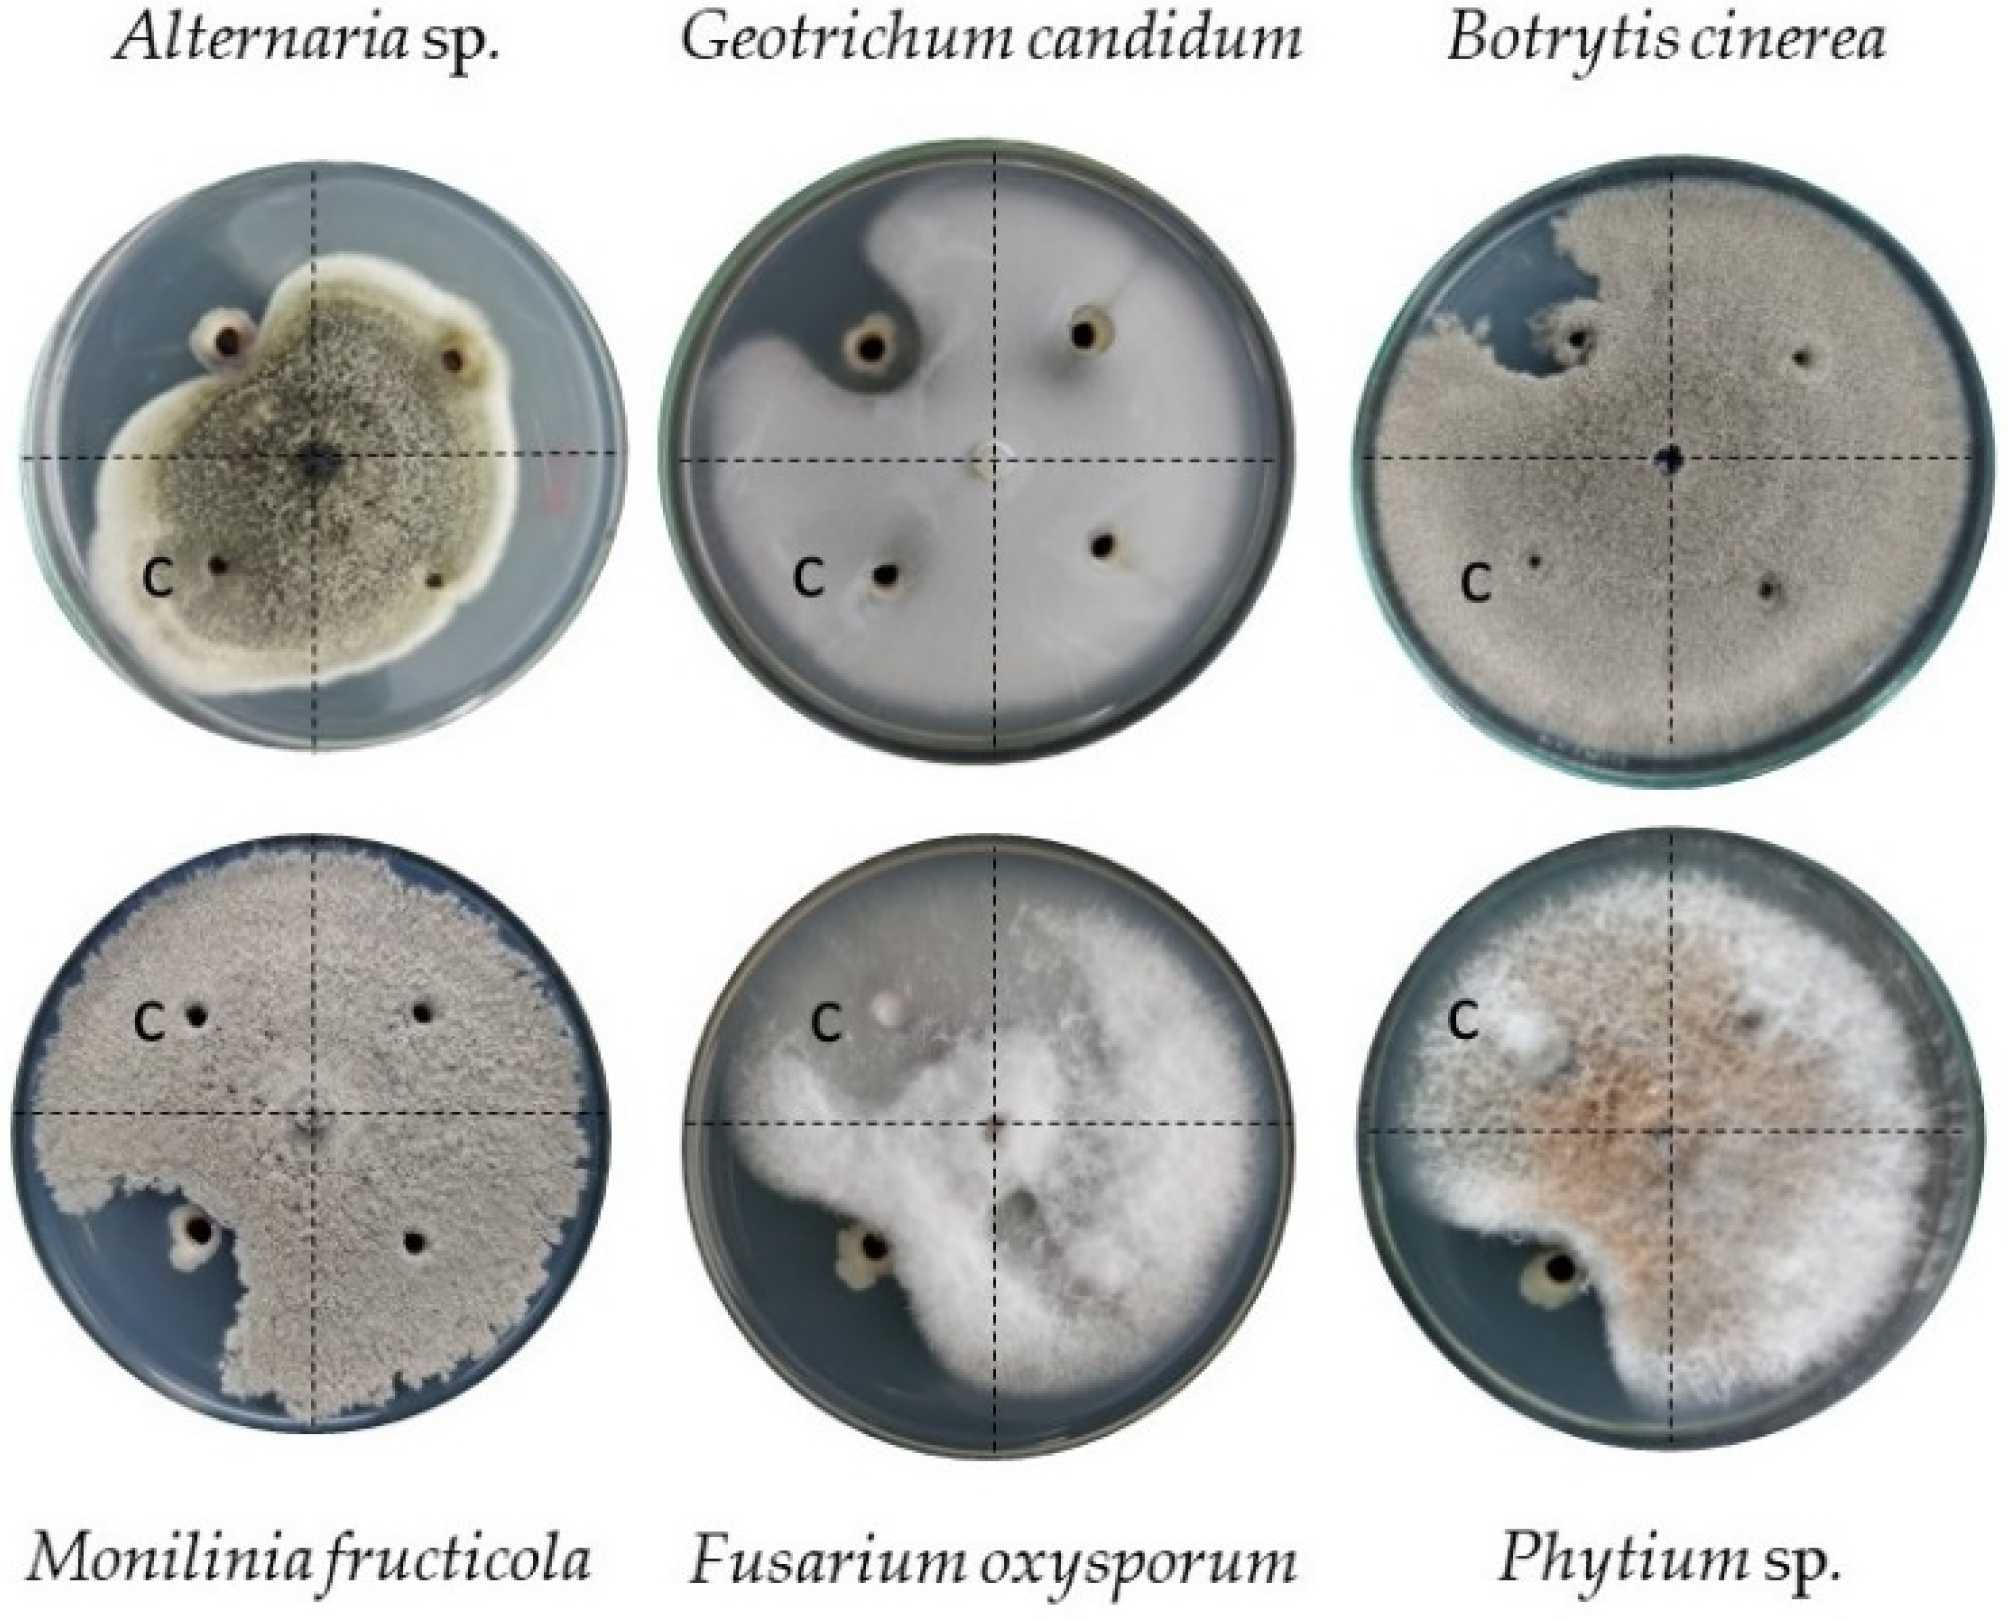
Diversity 14 00388 g005 Diversity 14 00388 g005

Bioprospecting of Plant Growth-Promoting Traits of Pseudomonas sp. Strain C3 Isolated from the Atacama Desert: Molecular and Culture-Based Analysis
Abstract
1. Introduction
2. Materials and Methods
2.1. Sampling Site Description
2.2. Culture, DNA Isolation, and Whole-Genome Sequencing
2.3. Genome Assembly and Annotation
2.4. Taxonomic Identification of the Complete Genome
2.5. Identification of Metabolic Pathways and Specialized Metabolites
2.6. In Vitro Growth Inhibition of Phytopathogenic Fungi
2.7. In Vitro Identification of Plant Growth-Promoting Traits
2.8. Detection of In Vitro Hydrolytic Activity
3. Results
3.1. Genome Assembly and Annotation
3.2. Molecular Analysis of Metabolites and Metabolic Pathways
3.3. In Vitro Antifungal Activity of Pseudomonas sp. Strain C3
4. Discussion
5. Conclusions
Supplementary Materials
Author Contributions
Funding
Institutional Review Board Statement
Data Availability Statement
Conflicts of Interest
References
- Mendes, R.; Garbeva, P.; Raaijmakers, J.M. The rhizosphere microbiome: Significance of plant beneficial, plant pathogenic, and human pathogenic microorganisms. FEMS Microbiol. Rev. 2013, 37, 634–663. [Google Scholar] [CrossRef] [PubMed]
- Mendes, L.W.; Raaijmakers, J.M.; de Hollander, M.; Mendes, R.; Tsai, S.M. Influence of resistance breeding in common bean on rhizosphere microbiome composition and function. ISME J. 2018, 12, 212–224. [Google Scholar] [CrossRef] [PubMed]
- du Jardin, P. Plant biostimulants: Definition, concept, main categories and regulation. Sci. Hortic. 2015, 196, 3–14. [Google Scholar] [CrossRef]
- Goswami, D.; Dhandhukia, P.; Patel, P.; Thakker, J.N. Screening of PGPR from saline desert of Kutch: Growth promotion in Arachis hypogea by Bacillus licheniformis A2. Microbiol. Res. 2014, 169, 66–75. [Google Scholar] [CrossRef] [PubMed]
- Jorquera, M.A.; Inostroza, N.G.; Lagos, L.M.; Barra, P.J.; Marileo, L.G.; Rilling, J.I.; Campos, D.C.; Crowley, D.E.; Richardson, A.E.; Mora, M.L. Bacterial community structure and detection of putative plant growth-promoting rhizobacteria associated with plants grown in Chilean agro-ecosystems and undisturbed ecosystems. Biol. Fertil. Soils 2014, 50, 1141–1153. [Google Scholar] [CrossRef]
- Ibort, P.; Molina, S.; Ruiz-Lozano, J.M.; Aroca, R. Molecular Insights into the Involvement of a Never Ripe Receptor in the Interaction Between Two Beneficial Soil Bacteria and Tomato Plants Under Well-Watered and Drought Conditions. Mol. Plant-Microbe Interact. 2018, 31, 633–650. [Google Scholar] [CrossRef]
- Subramanian, P.; Kim, K.; Krishnamoorthy, R.; Mageswari, A.; Selvakumar, G.; Sa, T. Cold Stress Tolerance in Psychrotolerant Soil Bacteria and Their Conferred Chilling Resistance in Tomato (Solanum lycopersicum Mill.) under Low Temperatures. PLoS ONE 2016, 11, e0161592. [Google Scholar] [CrossRef]
- Ashrafuzzaman, M.; Hossen, F.A.; Razi Ismail, M.; Hoque, A.; Islam, M.Z.; Shahidullah, S.M.; Meon, S. Efficiency of plant growth-promoting rhizobacteria (PGPR) for the enhancement of rice growth. Afr. J. Biotechnol. 2010, 8, 1247–1252. [Google Scholar] [CrossRef]
- Lehman, R.M.; Cambardella, C.A.; Stott, D.E.; Acosta-Martinez, V.; Manter, D.K.; Buyer, J.S.; Maul, J.E.; Smith, J.L.; Collins, H.P.; Halvorson, J.J.; et al. Understanding and Enhancing Soil Biological Health: The Solution for Reversing Soil Degradation. Sustainability 2015, 7, 988–1027. [Google Scholar] [CrossRef]
- Teale, W.D.; Paponov, I.A.; Palme, K. Auxin in action: Signalling, transport and the control of plant growth and development. Nat. Rev. Mol. Cell Biol. 2006, 7, 847–859. [Google Scholar] [CrossRef]
- Glick, B.R.; Todorovic, B.; Czarny, J.; Cheng, Z.; Duan, J.; McConkey, B. Promotion of Plant Growth by Bacterial ACC Deaminase. Crit. Rev. Plant Sci. 2007, 26, 227–242. [Google Scholar] [CrossRef]
- Krey, T.; Vassilev, N.; Baum, C.; Eichler-Löbermann, B. Effects of long-term phosphorus application and plant-growth promoting rhizobacteria on maize phosphorus nutrition under field conditions. Eur. J. Soil Biol. 2013, 55, 124–130. [Google Scholar] [CrossRef]
- Bhattacharjee, R.B.; Singh, A.; Mukhopadhyay, S.N. Use of nitrogen-fixing bacteria as biofertiliser for non-legumes: Prospects and challenges. Appl. Microbiol. Biotechnol. 2008, 80, 199–209. [Google Scholar] [CrossRef] [PubMed]
- Ansari, R.A.; Mahmood, I.; Rizvi, R.; Sumbul, A. Safiuddin Siderophores: Augmentation of soil health and crop productivity. In Probiotics in Agroecosystem; Springer: Singapore, 2017; pp. 291–312. [Google Scholar] [CrossRef]
- Mavrodi, O.V.; McSpadden Gardener, B.B.; Mavrodi, D.V.; Bonsall, R.F.; Weller, D.M.; Thomashow, L.S. Genetic diversity of phlD from 2,4-diacetylphloroglucinol-producing fluorescent Pseudomonas spp. Phytopathology 2001, 91, 35–42. [Google Scholar] [CrossRef]
- Weller, D.M.; Landa, B.B.; Mavrodi, O.V.; Schroeder, K.L.; De La Fuente, L.; Blouin Bankhead, S.; Allende Molar, R.; Bonsall, R.F.; Mavrodi, D.V.; Thomashow, L.S. Role of 2,4-diacetylphloroglucinol-producing fluorescent Pseudomonas spp. in the defense of plant roots. Plant Biol. 2007, 9, 4–20. [Google Scholar] [CrossRef]
- Almario, J.; Bruto, M.; Vacheron, J.; Prigent-Combaret, C.; Moënne-Loccoz, Y.; Muller, D. Distribution of 2,4-diacetylphloroglucinol biosynthetic genes among the Pseudomonas spp. Reveals unexpected Polyphyletism. Front. Microbiol. 2017, 8, 1218. [Google Scholar] [CrossRef]
- Zhao, H.; Liu, Y.P.; Zhang, L.Q. In silico and genetic analyses of cyclic lipopeptide synthetic gene clusters in Pseudomonas sp. 11K1. Front. Microbiol. 2019, 10, 544. [Google Scholar] [CrossRef]
- Zhang, L.; Chen, W.; Jiang, Q.; Fei, Z.; Xiao, M. Genome analysis of plant growth-promoting rhizobacterium Pseudomonas chlororaphis subsp. aurantiaca JD37 and insights from comparasion of genomics with three Pseudomonas strains. Microbiol. Res. 2020, 237, 126483. [Google Scholar] [CrossRef]
- Liang, J.; Wang, S.; Yiming, A.; Fu, L.; Nie, W.; Chen, G.; Zhu, B. Genome resource for Pseudomonas sp. strain L22-9: A potential novel species with antifungal activity. Phytopathology 2021, 111, 425–428. [Google Scholar] [CrossRef]
- Yang, Y.; Babich, O.O.; Sukhikh, S.A.; Zimina, M.I.; Milentyeva, I.S. Antibiotic activity and resistance of lactic acid bacteria and other antagonistic bacteriocin-producing microorganisms. Foods Raw Mater. 2020, 8, 377–384. [Google Scholar] [CrossRef]
- Marcoleta, A.E.; Arros, P.; Varas, M.A.; Costa, J.; Rojas-Salgado, J.; Berríos-Pastén, C.; Tapia-Fuentes, S.; Silva, D.; Fierro, J.; Canales, N.; et al. The highly diverse Antarctic Peninsula soil microbiota as a source of novel resistance genes. Sci. Total Environ. 2022, 810, 152003. [Google Scholar] [CrossRef] [PubMed]
- Aguila-Torres, P.; Maldonado, J.; Gaete, A.; Figueroa, J.; González, A.; Miranda, R.; González-Stegmaier, R.; Martin, C.; González, M. Biochemical and Genomic Characterization of the Cypermethrin-Degrading and Biosurfactant-Producing Bacterial Strains Isolated from Marine Sediments of the Chilean Northern Patagonia. Mar. Drugs 2020, 18, 252. [Google Scholar] [CrossRef] [PubMed]
- Kumar, U.; Panneerselvam, P.; Banik, A.; Annapurna, K. Lower Frequency and Diversity of Antibiotic-Producing Fluorescent Pseudomonads in Rhizosphere of Indian Rapeseed–Mustard (Brassica juncea L. Czern.). Proc. Natl. Acad. Sci. India Sect. B Biol. Sci. 2018, 88, 579–586. [Google Scholar] [CrossRef]
- Biessy, A.; Filion, M. Phloroglucinol Derivatives in Plant-Beneficial Pseudomonas spp.: Biosynthesis, Regulation, and Functions. Metabolites 2021, 11, 182. [Google Scholar] [CrossRef]
- Ambrosini, A.; Passaglia, L.M.P. Plant Growth—Promoting Bacteria (PGPB): Isolation and Screening of PGP Activities. Curr. Protoc. Plant Biol. 2017, 2, 190–209. [Google Scholar] [CrossRef]
- Li, S.J.; Hua, Z.S.; Huang, L.N.; Li, J.; Shi, S.H.; Chen, L.X.; Kuang, J.L.; Liu, J.; Hu, M.; Shu, W.S. Microbial communities evolve faster in extreme environments. Sci. Rep. 2014, 4, 6205. [Google Scholar] [CrossRef]
- Azua-Bustos, A.; González-Silva, C.; Arenas-Fajardo, C.; Vicuña, R. Extreme environments as potential drivers of convergent evolution by exaptation: The Atacama Desert Coastal Range case. Front. Microbiol. 2012, 3, 426. [Google Scholar] [CrossRef]
- Crits-Christoph, A.; Robinson, C.K.; Barnum, T.; Fricke, W.F.; Davila, A.F.; Jedynak, B.; McKay, C.P.; DiRuggiero, J. Colonization patterns of soil microbial communities in the Atacama Desert. Microbiome 2013, 1, 28. [Google Scholar] [CrossRef]
- Mandakovic, D.; Maldonado, J.; Pulgar, R.; Cabrera, P.; Gaete, A.; Urtuvia, V.; Seeger, M.; Cambiazo, V.; González, M. Microbiome analysis and bacterial isolation from Lejía Lake soil in Atacama Desert. Extremophiles 2018, 22, 665–673. [Google Scholar] [CrossRef]
- Díaz, F.P.; Frugone, M.; Gutiérrez, R.A.; Latorre, C. Nitrogen cycling in an extreme hyperarid environment inferred from δ15N analyses of plants, soils and herbivore diet. Sci. Rep. 2016, 6, 22226. [Google Scholar] [CrossRef] [PubMed]
- Eshel, G.; Araus, V.; Undurraga, S.; Soto, D.C.; Moraga, C.; Montecinos, A.; Moyano, T.; Maldonado, J.; Díaz, F.P.; Varala, K.; et al. Plant ecological genomics at the limits of life in the Atacama Desert. Proc. Natl. Acad. Sci. USA 2021, 118, e2101177118. [Google Scholar] [CrossRef] [PubMed]
- Gaete, A.; Mandakovic, D.; González, M. Isolation and Identification of Soil Bacteria from Extreme Environments of Chile and Their Plant Beneficial Characteristics. Microorganisms 2020, 8, 1213. [Google Scholar] [CrossRef] [PubMed]
- Maza, F.; Maldonado, J.; Vásquez-Dean, J.; Mandakovic, D.; Gaete, A.; Cambiazo, V.; González, M. Soil bacterial communities from the Chilean Andean highlands: Taxonomic composition and culturability. Front. Bioeng. Biotechnol. 2019, 7, 10. [Google Scholar] [CrossRef] [PubMed]
- Mandakovic, D.; Cintolesi, Á.; Maldonado, J.; Mendoza, S.N.; Aïte, M.; Gaete, A.; Saitua, F.; Allende, M.; Cambiazo, V.; Siegel, A.; et al. Genome-scale metabolic models of Microbacterium species isolated from a high altitude desert environment. Sci. Rep. 2020, 10, 5560. [Google Scholar] [CrossRef]
- Manni, M.; Berkeley, M.R.; Seppey, M.; Simão, F.A.; Zdobnov, E.M. BUSCO update: Novel and streamlined workflows along with broader and deeper phylogenetic coverage for scoring of eukaryotic, prokaryotic, and viral genomes. Mol. Biol. Evol. 2021, 38, 4647–4654. [Google Scholar] [CrossRef]
- Hyatt, D.; Chen, G.L.; LoCascio, P.F.; Land, M.L.; Larimer, F.W.; Hauser, L.J. Prodigal: Prokaryotic gene recognition and translation initiation site identification. BMC Bioinform. 2010, 11, 119. [Google Scholar] [CrossRef]
- Carver, T.; Thomson, N.; Bleasby, A.; Berriman, M.; Parkhill, J. DNAPlotter: Circular and linear interactive genome visualization. Bioinformatics 2009, 25, 119–120. [Google Scholar] [CrossRef]
- Parks, D.H.; Imelfort, M.; Skennerton, C.T.; Hugenholtz, P.; Tyson, G.W. CheckM: Assessing the quality of microbial genomes recovered from isolates, single cells, and metagenomes. Genome Res. 2015, 25, 1043–1055. [Google Scholar] [CrossRef]
- Tatusova, T.; Dicuccio, M.; Badretdin, A.; Chetvernin, V.; Nawrocki, E.P.; Zaslavsky, L.; Lomsadze, A.; Pruitt, K.D.; Borodovsky, M.; Ostell, J. NCBI prokaryotic genome annotation pipeline. Nucleic Acids Res. 2016, 44, 6614–6624. [Google Scholar] [CrossRef]
- Meier-Kolthoff, J.P.; Göker, M. TYGS is an automated high-throughput platform for state-of-the-art genome-based taxonomy. Nat. Commun. 2019, 10, 2182. [Google Scholar] [CrossRef] [PubMed]
- Meier-Kolthoff, J.P.; Auch, A.F.; Klenk, H.P.; Göker, M. Genome sequence-based species delimitation with confidence intervals and improved distance functions. BMC Bioinform. 2013, 14, 60. [Google Scholar] [CrossRef] [PubMed]
- Meier-Kolthoff, J.P.; Carbasse, J.S.; Peinado-Olarte, R.L.; Göker, M. YGS and LPSN: A database tandem for fast and reliable genome-based classification and nomenclature of prokaryotes. Nucleic Acids Res. 2022, 50, D801–D807. [Google Scholar] [CrossRef] [PubMed]
- Lefort, V.; Desper, R.; Gascuel, O. FastME 2.0: A Comprehensive, Accurate, and Fast Distance-Based Phylogeny Inference Program. Mol. Biol. Evol. 2015, 32, 2798–2800. [Google Scholar] [CrossRef] [PubMed]
- Farris, J.S. Estimating Phylogenetic Trees from Distance Matrices. Am. Nat. 2015, 106, 645–668. [Google Scholar] [CrossRef]
- Kreft, L.; Botzki, A.; Coppens, F.; Vandepoele, K.; Van Bel, M. PhyD3: A phylogenetic tree viewer with extended phyloXML support for functional genomics data visualization. Bioinformatics 2017, 33, 2946–2947. [Google Scholar] [CrossRef]
- Aoki-Kinoshita, K.F.; Kanehisa, M. Gene annotation and pathway mapping in KEGG. Methods Mol. Biol. 2007, 396, 71–91. [Google Scholar] [CrossRef]
- Aramaki, T.; Blanc-Mathieu, R.; Endo, H.; Ohkubo, K.; Kanehisa, M.; Goto, S.; Ogata, H. KofamKOALA: KEGG Ortholog assignment based on profile HMM and adaptive score threshold. Bioinformatics 2020, 36, 2251–2252. [Google Scholar] [CrossRef]
- Blin, K.; Shaw, S.; Kloosterman, A.M.; Charlop-Powers, Z.; Van Wezel, G.P.; Medema, M.H.; Weber, T.H. General rights antiSMASH 6.0: Improving cluster detection and comparison capabilities antiSMASH 6.0: Improving cluster detection and comparison capabilities. Nucleic Acids Res. 2021, 49, W29–W35. [Google Scholar] [CrossRef]
- Buchfink, B.; Xie, C.; Huson, D.H. Fast and sensitive protein alignment using DIAMOND. Nat. Agron. 2014, 12, 59–60. [Google Scholar] [CrossRef]
- Chavera, G.F.S.; Macuer, M.A.; Torres, P.M. Endospore-Forming Bacteria Present in a Commercial Stabilized Poultry Manure Determines the Fusarium Biocontrol and the Tomato Growth Promotion. Agronomy 2020, 10, 1636. [Google Scholar] [CrossRef]
- Louden, B.C.; Haarmann, D.; Lynne, A.M. Use of Blue Agar CAS Assay for Siderophore Detection. J. Microbiol. Biol. Educ. 2011, 12, 51–53. [Google Scholar] [CrossRef] [PubMed]
- Jadhav, R.N. Isolation of rhizobia from soybean cultivated in latur area & study of its phosphate solubilization activity. Biosci. Discov. 2013, 4, 100–103. [Google Scholar]
- Wafula, E.N.; Murunga, S.; Nalianya Wafula, E.; Murunga, S.I.; Wafula, E.N. Isolation and Identification of Phosphate Solubilizing and Nitrogen-Fixing Bacteria from Lake Ol’Bolossat Sediments, Kenya. Mod. Appl. Sci. 2020, 14. [Google Scholar] [CrossRef]
- Widawati, S. Isolation of indole acetic acid (IAA) producing Bacillus siamensis from peat and optimization of the culture conditions for maximum IAA production. IOP Conf. Ser. Earth Environ. Sci. 2020, 572, 012025. [Google Scholar] [CrossRef]
- Saima; Kuddus, M.; Roohi; Ahmad, I.Z. Isolation of novel chitinolytic bacteria and production optimization of extracellular chitinase. J. Genet. Eng. Biotechnol. 2013, 11, 39–46. [Google Scholar] [CrossRef]
- Bhowmik, S.; Islam, S.; Ahmed, M.M.; Belal Hossain, M.; Hossain, M.A. Protease producing bacteria and activity in gut of tiger shrimp (Penaeus monodon). J. Fish. Aquat. Sci. 2015, 10, 489–500. [Google Scholar] [CrossRef][Green Version]
- Slifkin, M. Tween 80 opacity test responses of various Candida species. J. Clin. Microbiol. 2000, 38, 4626–4628. [Google Scholar] [CrossRef]
- Bowers, R.M.; Kyrpides, N.C.; Stepanauskas, R.; Harmon-Smith, M.; Doud, D.; Reddy, T.B.K.; Schulz, F.; Jarett, J.; Rivers, A.R.; Eloe-Fadrosh, E.A.; et al. Minimum information about a single amplified genome (MISAG) and a metagenome-assembled genome (MIMAG) of bacteria and archaea. Nat. Biotechnol. 2017, 35, 725–731. [Google Scholar] [CrossRef]
- Rutz, D.; Frasson, D.; Sievers, M.; Blom, J.; Rezzonico, F.; Pothier, J.F.; Smits, T.H.M. High-Quality Draft Genome Sequence of Pseudomonas wadenswilerensis CCOS 864 T. Microbiol. Resour. Announc. 2018, 7, e01059-18. [Google Scholar] [CrossRef]
- Izrael-Živković, L.; Beškoski, V.; Rikalović, M.; Kazazić, S.; Shapiro, N.; Woyke, T.; Gojgić-Cvijović, G.; Vrvić, M.M.; Maksimović, N.; Karadžić, I. High-quality draft genome sequence of Pseudomonas aeruginosa san ai, an environmental isolate resistant to heavy metals. Extremophiles 2019, 23, 399–405. [Google Scholar] [CrossRef] [PubMed]
- Tyc, O.; Song, C.; Dickschat, J.S.; Vos, M.; Garbeva, P. The Ecological Role of Volatile and Soluble Secondary Metabolites Produced by Soil Bacteria. Trends Microbiol. 2017, 25, 280–292. [Google Scholar] [CrossRef] [PubMed]
- Vurukonda, S.S.K.P.; Giovanardi, D.; Stefani, E. Plant Growth Promoting and Biocontrol Activity of Streptomyces spp. as Endophytes. Int. J. Mol. Sci. 2018, 19, 952. [Google Scholar] [CrossRef]
- Syed Ab Rahman, S.F.; Singh, E.; Pieterse, C.M.J.; Schenk, P.M. Emerging microbial biocontrol strategies for plant pathogens. Plant Sci. 2018, 267, 102–111. [Google Scholar] [CrossRef] [PubMed]
- Fei, B.; Xu, H.; Zhang, F.; Li, X.; Ma, S.; Cao, Y.; Xie, J.; Qiao, D.; Cao, Y. Relationship between Escherichia coli AppA phytase’s thermostability and salt bridges. J. Biosci. Bioeng. 2013, 115, 623–627. [Google Scholar] [CrossRef]
- Vuppada, R.K.; Hansen, C.R.; Strickland, K.A.P.; Kelly, K.M.; McCleary, W.R. Phosphate signaling through alternate conformations of the PstSCAB phosphate transporter. BMC Microbiol. 2018, 18, 8. [Google Scholar] [CrossRef] [PubMed]
- Blus-Kadosh, I.; Zilka, A.; Yerushalmi, G.; Banin, E. The Effect of pstS and phoB on Quorum Sensing and Swarming Motility in Pseudomonas aeruginosa. PLoS ONE 2013, 8, e74444. [Google Scholar] [CrossRef]
- Wu, H.; Kosaka, H.; Kato, J.; Kuroda, A.; Ikeda, T.; Takiguchi, N.; Ohtake, H. Cloning and characterization of Pseudomonas putida genes encoding the phosphate-specific transport system. J. Biosci. Bioeng. 1999, 87, 273–279. [Google Scholar] [CrossRef]
- Clarke, T.; Tari, L.; Vogel, H. Structural Biology of Bacterial Iron Uptake Systems. Curr. Top. Med. Chem. 2005, 1, 7–30. [Google Scholar] [CrossRef]
- Schalk, I.J.; Guillon, L. Fate of ferrisiderophores after import across bacterial outer membranes: Different iron release strategies are observed in the cytoplasm or periplasm depending on the siderophore pathways. Amino Acids 2013, 44, 1267–1277. [Google Scholar] [CrossRef]
- Noinaj, N.; Guillier, M.; Barnard, T.J.; Buchanan, S.K. TonB-Dependent Transporters: Regulation, Structure, and Function. Annu. Rev. Microbiol. 2010, 64, 43–60. [Google Scholar] [CrossRef] [PubMed]
- Cartron, M.L.; Maddocks, S.; Gillingham, P.; Craven, C.J.; Andrews, S.C. Feo—Transport of ferrous iron into bacteria. BioMetals 2006, 19, 143–157. [Google Scholar] [CrossRef] [PubMed]
- Lau, C.K.Y.; Krewulak, K.D.; Vogel, H.J. Bacterial ferrous iron transport: The Feo system. FEMS Microbiol. Rev. 2016, 40, 273–298. [Google Scholar] [CrossRef]
- Pasqua, M.; Visaggio, D.; Sciuto, A.L.; Genah, S.; Banin, E.; Visca, P.; Imperi, F. Ferric Uptake Regulator Fur Is Conditionally Essential in Pseudomonas aeruginosa. J. Bacteriol. 2017, 199, 22. [Google Scholar] [CrossRef] [PubMed]
- Becerra, G.; Igeño, M.I.; Merchán, F.; Sánchez-Clemente, R.; Blasco, R. New evolving strategies revealed by transcriptomic analysis of a fur-mutant of the cyanotrophic bacterium Pseudomonas pseudoalcaligenes CECT 5344. Microb. Biotechnol. 2020, 13, 148–161. [Google Scholar] [CrossRef]
- Duca, D.R.; Glick, B.R. Indole-3-acetic acid biosynthesis and its regulation in plant-associated bacteria. Appl. Microbiol. Biotechnol. 2020, 104, 8607–8619. [Google Scholar] [CrossRef]
- McClerklin, S.A.; Lee, S.G.; Harper, C.P.; Nwumeh, R.; Jez, J.M.; Kunkel, B.N. Indole-3-acetaldehyde dehydrogenase-dependent auxin synthesis contributes to virulence of Pseudomonas syringae strain DC3000. PLoS Pathog. 2018, 14, e1006811. [Google Scholar] [CrossRef]
- Amina, M. Plant Growth-Promotion and IAA Secretion with Pseudomonas fluorescens and Pseudomonas putida Pseudomonas biofilm. J. Bot. Sci. 2017, 6. Available online: https://www.rroij.com/open-access/plant-growthpromotion-and-iaa-secretion-withpseudomonas-fluorescens-and-pseudomonas-putida-.pdf (accessed on 24 March 2022).
- Marzocchi, U.; Thorup, C.; Dam, A.S.; Schramm, A.; Risgaard-Petersen, N. Dissimilatory nitrate reduction by a freshwater cable bacterium. ISME J. 2021, 16, 50–57. [Google Scholar] [CrossRef]
- Huang, X.; Weisener, C.G.; Ni, J.; He, B.; Xie, D.; Li, Z. Nitrate assimilation, dissimilatory nitrate reduction to ammonium, and denitrification coexist in Pseudomonas putida Y-9 under aerobic conditions. Bioresour. Technol. 2020, 312, 123597. [Google Scholar] [CrossRef]
- Yan, L.; Wang, C.; Jiang, J.; Liu, S.; Zheng, Y.; Yang, M.; Zhang, Y. Nitrate removal by alkali-resistant Pseudomonas sp. XS-18 under aerobic conditions: Performance and mechanism. Bioresour. Technol. 2022, 344, 126175. [Google Scholar] [CrossRef] [PubMed]
- Nelkner, J.; Tejerizo, G.T.; Hassa, J.; Lin, T.W.; Witte, J.; Verwaaijen, B.; Winkler, A.; Bunk, B.; Spröer, C.; Overmann, J.; et al. Genetic Potential of the Biocontrol Agent Pseudomonas brassicacearum (Formerly P. trivialis) 3Re2-7 Unraveled by Genome Sequencing and Mining, Comparative Genomics and Transcriptomics. Genes 2019, 10, 601. [Google Scholar] [CrossRef] [PubMed]
- Zhang, Q.X.; Kong, X.W.; Li, S.Y.; Chen, X.J.; Chen, X.J. Antibiotics of Pseudomonas protegens FD6 are essential for biocontrol activity. Australas. Plant Pathol. 2020, 49, 307–317. [Google Scholar] [CrossRef]
- Dutta, S.; Yu, S.-M.; Lee, Y.H. Assessment of the Contribution of Antagonistic Secondary Metabolites to the Antifungal and Biocontrol Activities of Pseudomonas fluorescens NBC275. Plant Pathol. J. 2020, 36, 491. [Google Scholar] [CrossRef]
- Talkal, R.; Tikariha, H.; Purohit, H. An Approach to In Silico Dissection of Bacterial Intelligence Through Selective Genomic Tools. Indian J. Microbiol. 2018, 58, 278–286. [Google Scholar] [CrossRef]
- Daura-Pich, O.; Hernández, I.; Pinyol-Escala, L.; Lara, J.M.; Martínez-Servat, S.; Fernández, C.; López-García, B. No antibiotic and toxic metabolites produced by the biocontrol agent Pseudomonas putida strain B2017. FEMS Microbiol. Lett. 2020, 367, fnaa075. [Google Scholar] [CrossRef]
- Krechel, A.; Faupel, A.; Hallmann, J.; Ulrich, A.; Berg, G. Potato-associated bacteria and their antagonistic potential towards plant-pathogenic fungi and the plant-parasitic nematode Meloidogyne incognita (Kofoid & White) Chitwood. Can. J. Microbiol. 2011, 48, 772–786. [Google Scholar] [CrossRef]
- Moronta-Barrios, F.; Gionechetti, F.; Pallavicini, A.; Marys, E.; Venturi, V. Bacterial Microbiota of Rice Roots: 16S-Based Taxonomic Profiling of Endophytic and Rhizospheric Diversity, Endophytes Isolation and Simplified Endophytic Community. Microorganisms 2018, 6, 14. [Google Scholar] [CrossRef]
- Nishu, S.D.; Hyun, H.R.; Lee, T.K. Complete genome sequence of drought tolerant plant growth-promoting rhizobacterium Glutamicibacter halophytocola DR408. Microbiol. Soc. Korea 2019, 55, 300–302. [Google Scholar] [CrossRef]
- Deng, P.; Wang, X.; Baird, S.M.; Lu, S.E. Complete genome of Pseudomonas chlororaphis strain UFB2, a soil bacterium with antibacterial activity against bacterial canker pathogen of tomato. Stand. Genom. Sci. 2015, 10, 117. [Google Scholar] [CrossRef]
- Loper, J.E.; Hassan, K.A.; Mavrodi, D.V.; Davis, E.W.; Lim, C.K.; Shaffer, B.T.; Elbourne, L.D.H.; Stockwell, V.O.; Hartney, S.L.; Breakwell, K.; et al. Comparative Genomics of Plant-Associated Pseudomonas spp.: Insights into Diversity and Inheritance of Traits Involved in Multitrophic Interactions. PLoS Genet. 2012, 8, e1002784. [Google Scholar] [CrossRef] [PubMed]
- Ortet, P.; Barakat, M.; Lalaouna, D.; Fochesato, S.; Barbe, V.; Vacherie, B.; Santaella, C.; Heulin, T.; Achouak, W. Complete Genome Sequence of a Beneficial Plant Root-Associated Bacterium, Pseudomonas brassicacearum. J. Bacteriol. 2011, 193, 3146. [Google Scholar] [CrossRef] [PubMed][Green Version]
- Price, M.N.; Wetmore, K.M.; Waters, R.J.; Callaghan, M.; Ray, J.; Liu, H.; Kuehl, J.V.; Melnyk, R.A.; Lamson, J.S.; Suh, Y.; et al. Mutant phenotypes for thousands of bacterial genes of unknown function. Nature 2018, 557, 503–509. [Google Scholar] [CrossRef] [PubMed]
- Chae, D.H.; Kim, D.R.; Cheong, M.S.; Lee, Y.B.; Kwak, Y.S. Investigating the Induced Systemic Resistance Mechanism of 2,4-Diacetylphloroglucinol (DAPG) using DAPG Hydrolase-Transgenic Arabidopsis. Plant Pathol. J. 2020, 36, 255. [Google Scholar] [CrossRef] [PubMed]
- Gong, L.; Tan, H.; Chen, F.; Li, T.; Zhu, J.; Jian, Q.; Yuan, D.; Xu, L.; Hu, W.; Jiang, Y.; et al. Novel synthesized 2, 4-DAPG analogues: Antifungal activity, mechanism and toxicology. Sci. Rep. 2016, 6, 32266. [Google Scholar] [CrossRef] [PubMed]
- Sharma, P.; Verma, P.P.; Kaur, M. Identification of secondary metabolites produced byfluorescent Pseudomonads for controlling fungal pathogensof apple. Indian Phytopathol. 2017, 70, 452–456. [Google Scholar] [CrossRef]
- Müller, T.; Behrendt, U.; Ruppel, S.; Von Der Waydbrink, G.; Müller, M.E.H. Fluorescent Pseudomonads in the Phyllosphere of Wheat: Potential Antagonists against Fungal Phytopathogens. Curr. Microbiol. 2016, 72, 383–389. [Google Scholar] [CrossRef]
- Nesemann, K.; Braus-Stromeyer, S.A.; Harting, R.; Höfer, A.; Kusch, H.; Ambrosio, A.B.; Timpner, C.; Braus, G.H. Fluorescent pseudomonads pursue media-dependent strategies to inhibit growth of pathogenic Verticillium fungi. Appl. Microbiol. Biotechnol. 2017, 102, 817–831. [Google Scholar] [CrossRef]
- Suresh, P.; Varathraju, G.; Shanmugaiah, V.; Almaary, K.S.; Elbadawi, Y.B.; Mubarak, A. Partial purification and characterization of 2, 4-diacetylphloroglucinol producing Pseudomonas fluorescens VSMKU3054 against bacterial wilt disease of tomato. Saudi J. Biol. Sci. 2021, 28, 2155–2167. [Google Scholar] [CrossRef]
- Patel, J.K.; Archana, G. Engineered production of 2,4-diacetylphloroglucinol in the diazotrophic endophytic bacterium Pseudomonas sp. WS5 and its beneficial effect in multiple plant-pathogen systems. Appl. Soil Ecol. 2018, 124, 34–44. [Google Scholar] [CrossRef]
- Weller, D.M.; Mavrodi, D.V.; van Pelt, J.A.; Pieterse, C.M.J.; van Loon, L.C.; Bakker, P.A.H.M. Induced Systemic Resistance in Arabidopsis thaliana against Pseudomonas syringae pv. tomato by 2,4-Diacetylphloroglucinol-Producing Pseudomonas fluorescens. Phytopathology 2012, 102, 403–412. [Google Scholar] [CrossRef] [PubMed]
- Sacherer, P.; Défago, G.; Haas, D. Extracellular protease and phospholipase C are controlled by the global regulatory gene gacA in the biocontrol strain Pseudomonas fluorescens CHA0. FEMS Microbiol. Lett. 1994, 116, 155–160. [Google Scholar] [CrossRef] [PubMed]
- Duffy, B.K.; Defago, G. Controlling instability in gacS-gacA regulatory genes during inoculant production of Pseudomonas fluorescens biocontrol strains. Appl. Environ. Microbiol. 2000, 66, 3142–3150. [Google Scholar] [CrossRef] [PubMed]
- Van Den Broek, D.; Chin-A-Woeng, T.F.C.; Eijkemans, K.; Mulders, I.H.M.; Bloemberg, G.V.; Lugtenberg, B.J.J. Biocontrol Traits of Pseudomonas spp. Are Regulated by Phase Variation. Mol. Plant-Microbe Interact. 2007, 16, 1003–1012. [Google Scholar] [CrossRef][Green Version]

| Features | Chromosome |
|---|---|
| ID | C3 |
| Marker lineage | f__Pseudomonadaceae (UID4490) |
| %Completeness | 99.38 |
| %Contamination | 0.1 |
| %Strain heterogeneity | 0 |
| N50 | 65,108 |
| Sequences | 129 |
| %GC | 61.37 |
| Total length | 5,677,066 |
| Predicted genes | 5126 |
| CDS | 5066 |
| Proteins | 4971 |
| rRNA | 2 |
| tRNA | 55 |
| Genome Quality | High-quality draft |
| Region | Type | From | To | Most Similar Know Cluster | Similarity |
|---|---|---|---|---|---|
| 12.1 | Arylpolyene | 29,041 | 72,652 | APE Vf | 45% |
| 15.1 | NAGGN | 31,762 | 46,460 | − | − |
| 17.1 | Butyrolactone | 54,893 | 68,324 | − | − |
| 29.1 | Betalactone | 7324 | 87,127 | Fengycin | 13% |
| 30.1 | Redox-cofactor | 14,343 | 36,490 | Lankacidin C | 13% |
| 31.1 | RiPP-like | 2417 | 14,033 | − | − |
| 39.1 | NRPS | 1 | 59,934 | Crochelin A | 7% |
| 46.1 | RiPP-like | 1 | 6516 | − | − |
| 46.2 | T3PKS | 26,434 | 67,483 | 2,4-diacetylphloroglucinol | 100% |
| 59.1 | NRPS-like | 18,081 | 55,356 | − | − |
| 69.1 | NRPS-like | 1 | 27,536 | Fragin | 37% |
| 72.1 | Lanthipeptide-class-ii | 25,424 | 48,519 | − | − |
| 104.1 | Siderophore | 5099 | 24,019 | − | − |
| Metabolics Traits | Annotation Entry (KO) | Gene | Product Name | |
|---|---|---|---|---|
| Plant growth promoting | Phosphate uptake | K02040 | pstS | phosphate transport system substrate-binding protein |
| K02038 | pstA | phosphate transport system permease protein | ||
| K02037 | pstC | phosphate transport system permease protein | ||
| K02036 | pstB | phosphate transport system ATP-binding protein | ||
| K01077 | phoA | alkaline phosphatase | ||
| K07636 | phoR | phosphate regulon sensor histidine kinase PhoR | ||
| K02039 | phoU | phosphate transport system protein | ||
| K07657 | phoB | phosphate regulon response regulator PhoB | ||
| Iron Uptake | K02015 | fhuB | iron complex transport system permease protein | |
| K10829 | fhuC | ferric hydroxamate transport system ATP-binding protein | ||
| K02016 | fhuD | iron complex transport system substrate-binding protein | ||
| K04758 | feoA | ferrous iron transport protein A | ||
| K03711 | Fur | Fur family transcriptional regulator, ferric uptake regulator | ||
| IAA | K00274 | MAO | monoamine oxidase | |
| K00138 | aldB | aldehyde dehydrogenase | ||
| Nitrate reduction | K02567 | napA | nitrate reductase (cytochrome) | |
| K02568 | napB | nitrate reductase (cytochrome), electron transfer subunit | ||
| K00362 | nirB | nitrite reductase (NADH) large subunit | ||
| K00363 | nirD | nitrite reductase (NADH) small subunit | ||
| ACCd | K01505 | acdS | 1-aminocyclopropane-1-carboxylate deaminase | |
| Biocontroler | Siderophore (Enterochelin) | K02362 | entD | enterobactin synthetase component D |
| K02363 | entE | 2,3-dihydroxybenzoate---[aryl-carrier protein] ligase | ||
| K01252 | entB | bifunctional isochorismate lyase/aryl carrier protein | ||
| K02364 | entF | L-serine---[L-seryl-carrier protein] ligase | ||
| 2,4-DAPG | K15431 | phlD | phloroglucinol synthase | |
| K22840 | phlB | 2-acetylphloroglucinol acetyltransferase | ||
| K22839 | phlC | 2-acetylphloroglucinol acetyltransferase | ||
| K22838 | phlA | 2-acetylphloroglucinol acetyltransferase | ||
| n.a. | phlF | TetR/AcrR family transcriptional regulator | ||
| K23519 | phlG | 2,4-diacetylphloroglucinol hydrolase | ||
| n.a. | phlH | TetR/AcrR family transcriptional regulator | ||
| HCN | K10816 | hcnC | hydrogen cyanide synthase | |
| K10815 | hcnB | hydrogen cyanide synthase | ||
| K10814 | hcnA | hydrogen cyanide synthase | ||
| Protease | K01438 | argE | acetylornithine deacetylase | |
| K07678 | gacS | sensor histidine kinase | ||
| K07689 | gacA | invasion response regulator |
Publisher’s Note: MDPI stays neutral with regard to jurisdictional claims in published maps and institutional affiliations. |
© 2022 by the authors. Licensee MDPI, Basel, Switzerland. This article is an open access article distributed under the terms and conditions of the Creative Commons Attribution (CC BY) license (https://creativecommons.org/licenses/by/4.0/).
Share and Cite
Gaete, A.; Andreani-Gerard, C.; Maldonado, J.E.; Muñoz-Torres, P.A.; Sepúlveda-Chavera, G.F.; González, M. Bioprospecting of Plant Growth-Promoting Traits of Pseudomonas sp. Strain C3 Isolated from the Atacama Desert: Molecular and Culture-Based Analysis. Diversity 2022, 14, 388. https://doi.org/10.3390/d14050388
Gaete A, Andreani-Gerard C, Maldonado JE, Muñoz-Torres PA, Sepúlveda-Chavera GF, González M. Bioprospecting of Plant Growth-Promoting Traits of Pseudomonas sp. Strain C3 Isolated from the Atacama Desert: Molecular and Culture-Based Analysis. Diversity. 2022; 14(5):388. https://doi.org/10.3390/d14050388
Chicago/Turabian StyleGaete, Alexis, Constanza Andreani-Gerard, Jonathan E. Maldonado, Patricio A. Muñoz-Torres, Germán F. Sepúlveda-Chavera, and Mauricio González. 2022. "Bioprospecting of Plant Growth-Promoting Traits of Pseudomonas sp. Strain C3 Isolated from the Atacama Desert: Molecular and Culture-Based Analysis" Diversity 14, no. 5: 388. https://doi.org/10.3390/d14050388
APA StyleGaete, A., Andreani-Gerard, C., Maldonado, J. E., Muñoz-Torres, P. A., Sepúlveda-Chavera, G. F., & González, M. (2022). Bioprospecting of Plant Growth-Promoting Traits of Pseudomonas sp. Strain C3 Isolated from the Atacama Desert: Molecular and Culture-Based Analysis. Diversity, 14(5), 388. https://doi.org/10.3390/d14050388

